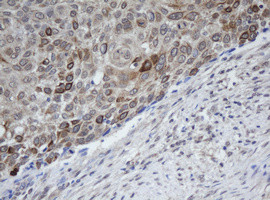
MAGEB1 Antibody in Immunohistochemistry (Paraffin) (IHC (P))

Search
OriGene
MAGEB1 Monoclonal Antibody (OTI2B12), TrueMAB™
{{$productOrderCtrl.translations['antibody.pdp.commerceCard.promotion.promotions']}}
{{$productOrderCtrl.translations['antibody.pdp.commerceCard.promotion.viewpromo']}}
{{$productOrderCtrl.translations['antibody.pdp.commerceCard.promotion.promocode']}}: {{promo.promoCode}} {{promo.promoTitle}} {{promo.promoDescription}}. {{$productOrderCtrl.translations['antibody.pdp.commerceCard.promotion.learnmore']}}
产品信息
CF800473
种属反应
宿主/亚型
分类
类型
克隆号
抗原
偶联物
形式
浓度
纯化类型
保存液
内含物
保存条件
运输条件
产品详细信息
For reconstitution, we recommend adding 100 µL distilled water to a final antibody concentration of about 1 mg/mL. To use this carrier-free antibody for conjugation experiments, we strongly recommend performing another round of desalting. (Zeba Spin Desalting Columns, 7KMWCO, 0.5 mL, Product # 89882)
靶标信息
This gene is a member of the MAGEB gene family. The members of this family have their entire coding sequences located in the last exon, and the encoded proteins show 50 to 68% sequence identity to each other. The promoters and first exons of the MAGEB genes show considerable variability, suggesting that the existence of this gene family enables the same function to be expressed under different transcriptional controls. This gene is localized in the DSS (dosage-sensitive sex reversal) critical region, and expressed in testis and in a significant fraction of tumors of various histological types. This gene and other MAGEB members are clustered on chromosome Xp22-p21. Multiple alternatively spliced transcript variants encoding the same protein have been found for this gene, however, the full length nature of some variants has not been defined.
仅用于科研。不用于诊断过程。未经明确授权不得转售。
篇参考文献 (0)
生物信息学
蛋白别名: Cancer/testis antigen 3.1; cancer/testis antigen family 3, member 1; CT3.1; DAM10; DSS-AHC critical interval MAGE superfamily 10; DSS/AHC critical interval MAGE superfamily 10; MAGE-B1 antigen; MAGE-XP antigen; melanoma antigen family B, 1; melanoma antigen family B1; Melanoma-associated antigen B1; MGC9322
基因别名: CT3.1; DAM10; MAGE-Xp; MAGEB1; MAGEL1; MAGEXP
UniProt ID: (Human) P43366
Entrez Gene ID: (Human) 4112